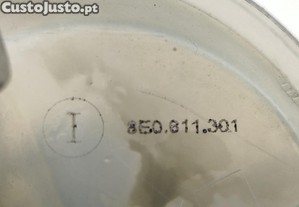
imagem_3

Servo Freio Com Bomba De Freio Volkswagen Passat (
Preço: 62 €Servo Freio Com Bomba De Freio Volkswagen Passat (
Especificações
- TUATUA20220118000030
- TipoVenda
- ConcelhoSanta Maria da Feira
- Id do anúncio44202295
- Id do anunciante262519
Descrição
Referência: 8D0612105F
Referência ATENA: 262519
Informação adicional da viatura
Intervalo de anos: 1996 - 2001
Motorização: 1.9 TDI
Combustivel: Diesel
Número de portas: 4
Preço com IVA incluído
Temos o prazer de informar que a Motivauto adquiriu recentemento o stock da Rautopeças.
Esta integração permite-nos expandir ainda mais o nosso compromisso eem fornecer peças usadas de qualidade.
VISITE A NOSSA LOJA ONLINE
Ganhe um Voucher de Férias com a Motivauto!
Na Motivauto, estamos sempre a pensar em si! Por isso, preparamos uma oferta especial para tornar as suas compras ainda mais recompensadoras.
Agora, ao comprar na nossa loja online, acumule compras até 1500eur e receba um voucher de férias para desfrutar de momentos inesquecíveis!
Como funciona?
Faça compras na nossa loja online entre 1 de fevereiro de 2025 e 30 de setembro de 2025.
Acumule compras até 1500eur e receba automaticamente o voucher de férias.
Utilize o voucher dentro do prazo e condições indicadas.
Não perca esta oportunidade! Compre já na Motivauto e comece a planear as suas próximas férias.
Termos e Condições:
O voucher é válido para utilização conforme indicado nas condições do mesmo.
Promoção válida apenas para compras acumuladas entre 1/2/2025 e 30/9/2025.
Aproveite esta oferta exclusiva e dê um toque especial às suas férias com a Motivauto!
?? Compre já na nossa loja online!
www.motivauto.pt
Coloque a referencia atena no campo de referencias do nosso site e pode efectuar a compra directamente!
910 198 880
914 759 539
[email escondido]
Centro de Abate Automovel
TUA: 2022011800030
Enviamos para todo o Continente, Ilhas e Europa;
Podem também contactar-nos através do contacto telefonico (Rede nacional)
Atendimento ao público, de segunda feira a sexta feira das 9:00 às 13:00 e das 14:00 às 19:00 e sábado das 9:00 às 13:00.
Peça de operador de desmantelamento licenciado, conforme alínea e) do nº 9 do art 87º do dec-lei nº152-D/2017 de 11 de dezembro.
A informação disponibilizada assim como as imagens, ainda que precisa, não dispensa a sua confirmação, nem poderá ser considerada vinculativa.
Referência ATENA: 262519
Informação adicional da viatura
Intervalo de anos: 1996 - 2001
Motorização: 1.9 TDI
Combustivel: Diesel
Número de portas: 4
Preço com IVA incluído
Temos o prazer de informar que a Motivauto adquiriu recentemento o stock da Rautopeças.
Esta integração permite-nos expandir ainda mais o nosso compromisso eem fornecer peças usadas de qualidade.
VISITE A NOSSA LOJA ONLINE
Ganhe um Voucher de Férias com a Motivauto!
Na Motivauto, estamos sempre a pensar em si! Por isso, preparamos uma oferta especial para tornar as suas compras ainda mais recompensadoras.
Agora, ao comprar na nossa loja online, acumule compras até 1500eur e receba um voucher de férias para desfrutar de momentos inesquecíveis!
Como funciona?
Faça compras na nossa loja online entre 1 de fevereiro de 2025 e 30 de setembro de 2025.
Acumule compras até 1500eur e receba automaticamente o voucher de férias.
Utilize o voucher dentro do prazo e condições indicadas.
Não perca esta oportunidade! Compre já na Motivauto e comece a planear as suas próximas férias.
Termos e Condições:
O voucher é válido para utilização conforme indicado nas condições do mesmo.
Promoção válida apenas para compras acumuladas entre 1/2/2025 e 30/9/2025.
Aproveite esta oferta exclusiva e dê um toque especial às suas férias com a Motivauto!
?? Compre já na nossa loja online!
www.motivauto.pt
Coloque a referencia atena no campo de referencias do nosso site e pode efectuar a compra directamente!
910 198 880
914 759 539
[email escondido]
Centro de Abate Automovel
TUA: 2022011800030
Enviamos para todo o Continente, Ilhas e Europa;
Podem também contactar-nos através do contacto telefonico (Rede nacional)
Atendimento ao público, de segunda feira a sexta feira das 9:00 às 13:00 e das 14:00 às 19:00 e sábado das 9:00 às 13:00.
Peça de operador de desmantelamento licenciado, conforme alínea e) do nº 9 do art 87º do dec-lei nº152-D/2017 de 11 de dezembro.
A informação disponibilizada assim como as imagens, ainda que precisa, não dispensa a sua confirmação, nem poderá ser considerada vinculativa.
Título Positivo
Anunciante desde Abr. 2011
Tempo de resposta superior a 1 hora Último acesso há mais de 1 dia
Tempo de resposta superior a 1 hora Último acesso há mais de 1 dia
Serviços adicionais
Verifique as melhores opções de crédito ou seguro para o seu caso.
Localização
Aveiro - Santa Maria da Feira
Título Positivo
Anunciante desde Abr. 2011
Tempo de resposta superior a 1 hora Último acesso há mais de 1 dia
Tempo de resposta superior a 1 hora Último acesso há mais de 1 dia